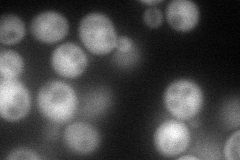
YMR289W
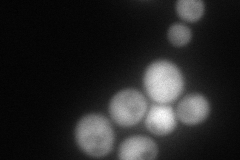
YMR289W
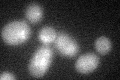
YMR289W
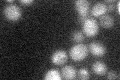
YMR289W

View description
Aminodeoxychorismate lyase (4-amino-4-deoxychorismate lyase), catalyzes the third step in para-aminobenzoic acid biosynthesis; involved in folic acid biosynthesis
Localization:
Intensity:
Fold change:
Significance:
-
C’ GFP library in SD

below threshold16.17 -
N' NOP1pr-GFP in SD
cytosol83.6538 -
N' TEF2pr-mCherry in SD
cytosol104.987 -
N' NATIVEpr-GFP in SD

below threshold25.8208 -
N' TEF2pr-VC and Cyto-VN in SD

#N/A0 -
C’ GFP library in SD+DTT
cytosol15.520.95No -
C’ GFP library in SD+H2O2

cytosol17.491.08No -
C’ GFP library in Starvation Media
cytosol27.081.67No -
C’ GFP library on the background of Pup2-DaMP

below threshold -
C’ GFP library on the background of CCT mutant

below threshold16.86391.04276No
